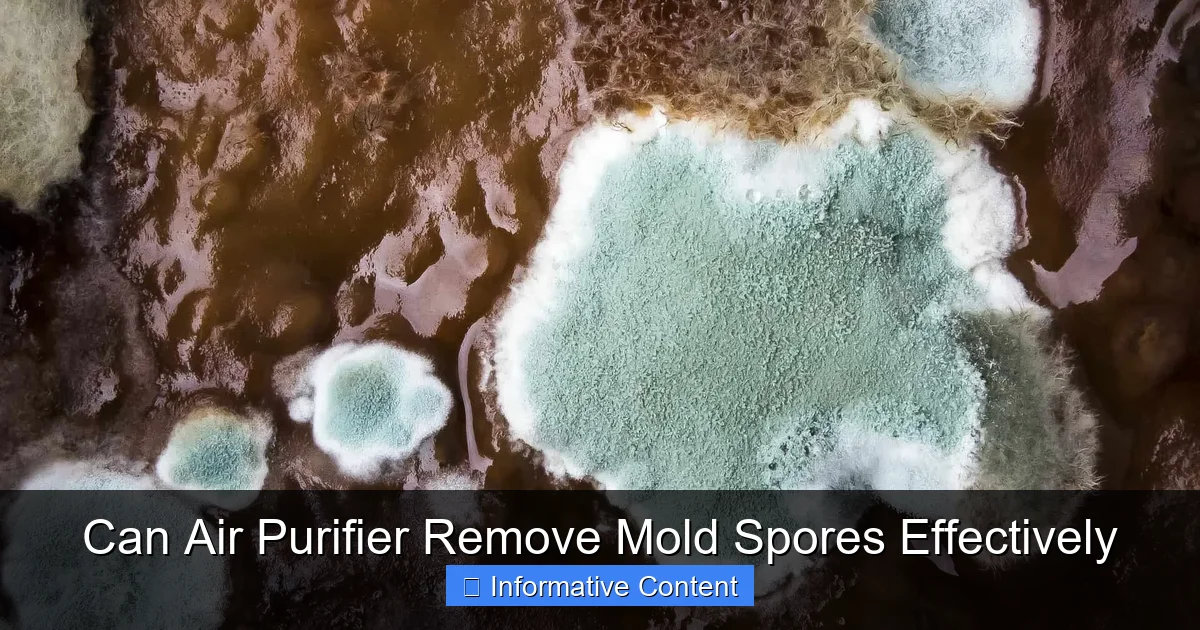
Can Air Purifier Remove Mold Spores Effectively

How to Measure a Room for an Air Purifier in 2026
February 13, 2026
Learn how to measure a room for an air purifier in 2026 with our expert guide to ensure optimal air quality and coverage in any space.

How to Measur for Air Purifier in 2026 Top Tips Revealed
February 13, 2026
Learn how to measur for air purifier in 2026 with expert tips on size, placement, and performance for cleaner, healthier indoor air.

How to Manufacture Air Purifier in 2026 Expert Guide
February 13, 2026
Discover how to manufacture air purifier units in 2026 with this expert guide covering design sourcing assembly testing and market strategies for success

How to Make Your Own Mold Air Purifiers in 2026
February 13, 2026
Discover how to make your own mold air purifiers in 2026 with simple DIY methods improve indoor air quality and reduce allergens effectively using proven tec…

How to Make Your Own Charcoal Air Purifier in 2026
February 13, 2026
Learn how to make your own charcoal air purifier in 2026 with simple, eco-friendly steps to improve indoor air quality naturally and affordably.

How to Make Your Own Air Purifier Using Water in 2026
February 13, 2026
Discover how to make your own air purifier using water in 2026 with this simple, eco-friendly DIY guide for cleaner indoor air.

How to Make Simple Air Purifier in 2026 Easy DIY Guide
February 13, 2026
Discover how to make simple air purifier at home with this easy DIY guide. Improve air quality affordably using basic materials and smart techniques.

How to Make Quiet Air Purifier in 2026 Top Tips Revealed
February 13, 2026
Discover how to make a quiet air purifier in 2026 with expert tips for better air quality and peaceful living. Simple, effective, and noise-free solutions.

How to Make Ozone Air Purifier in 2026 A Complete Guide
February 13, 2026
Discover how to make an ozone air purifier at home with our complete 2026 guide—safe, effective, and easy DIY steps included.
Basics

What Air Purifier Filter Fits Holmes HAP 2400B Find the Perfect Match Here
December 19, 2025
Find the perfect replacement filter for your Holmes HAP 2400B air purifier. Learn what air purifier filter fits Holmes HAP 2400B and enjoy cleaner air.

What Air Purifier Does NASA Use for Clean Space Air
December 19, 2025
Discover what air purifier NASA uses to maintain clean air in space. Explore the advanced technology ensuring astronaut safety and air quality in orbit.

What Air Purifier Does Consumer Reports Recommend for Clean Air
December 19, 2025
Discover what air purifier does Consumer Reports recommend for clean, healthy air—top-rated models tested for performance, efficiency, and reliability.

What Air Purifier Does Bryan Johnson Use for Clean Air
December 19, 2025
Discover what air purifier Bryan Johnson uses for pristine air quality and optimal health in his daily routine for clean living

What Air Purifier Does Your Home Need for Cleaner Air
December 18, 2025
Discover what air purifier does your home need for cleaner, healthier air. Compare top models, features, and benefits to breathe easier today.

What Air Purifier Do Hospitals Use for Clean Air
December 18, 2025
Discover what air purifier do hospitals use to maintain sterile environments and ensure clean, safe air for patients and staff.

What Air Purifier Do Doctors Recommend for Cleaner Air
December 18, 2025
Discover what air purifier do doctors recommend for cleaner, healthier air at home. Expert-backed choices for allergy relief and improved air quality.

What Air Purifier Do Allergists Recommend for Cleaner Air
December 18, 2025
Discover what air purifier do allergists recommend for cleaner air and reduced allergies expert-approved picks for healthier indoor air quality

What Air Purifier Do Experts Recommend for Cleaner Air
December 18, 2025
Discover what air purifier do experts recommend for cleaner air. Top-rated models for allergies dust and pet dander reviewed by professionals for healthier l…
Knowledgebase

Can Air Purifier Remove Mycotoxins Effectively
December 21, 2025
Discover if an air purifier can effectively remove mycotoxins from your home Learn how HEPA filters and advanced technologies combat these harmful airborne t…

Can Air Purifier Remove Mosquito and Improve Air Quality
December 21, 2025
Discover how an air purifier can remove mosquito and improve air quality effectively Learn key benefits and features for a healthier home environment today
Can Air Purifier Remove Mold Spores Effectively
December 21, 2025
Discover how air purifiers can effectively remove mold spores from your home improving air quality and reducing health risks with proven filtration technology

Can Air Purifier Remove Mold From Air A Complete Guide
December 21, 2025
Discover how air purifiers combat mold spores and improve indoor air quality. Learn if an air purifier can remove mold from air effectively with expert tips …

Can Air Purifier Remove Mold Discover the Truth Here
December 21, 2025
Can air purifier remove mold? Discover how effective air purifiers are at eliminating mold spores and improving indoor air quality.

Can Air Purifier Remove Formaldehyde Effectively
December 21, 2025
Can air purifier remove formaldehyde effectively? Discover how advanced filtration systems target harmful VOCs and improve indoor air quality for healthier l…

Can Air Purifier Remove Flu Virus Experts Reveal the Truth
December 21, 2025
Can air purifier remove flu virus? Experts reveal how HEPA filters and UV-C technology help reduce airborne flu particles for cleaner indoor air

Can Air Purifier Remove Dust Mites Effectively
December 21, 2025
Yes, an air purifier can remove dust mites and their allergens effectively, improving indoor air quality and reducing allergy symptoms for a healthier home.

Can Air Purifier Remove Dust and Improve Your Home Air Quality
December 21, 2025
Discover how an air purifier can remove dust and significantly improve your home air quality for a healthier living space

Can Air Purifier Remove Dog Smell Effectively
December 21, 2025
Discover how an air purifier can effectively remove dog smell from your home improving air quality and eliminating pet odors for good
Maintenance
No results found.


